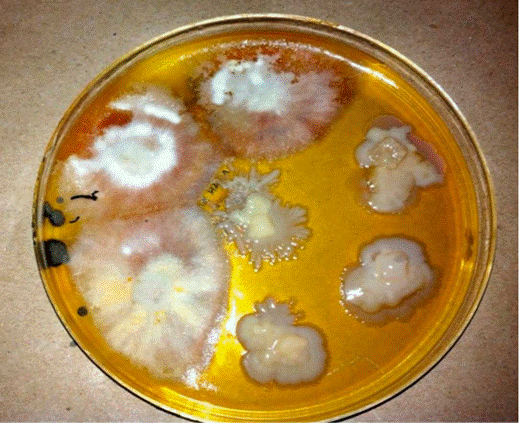
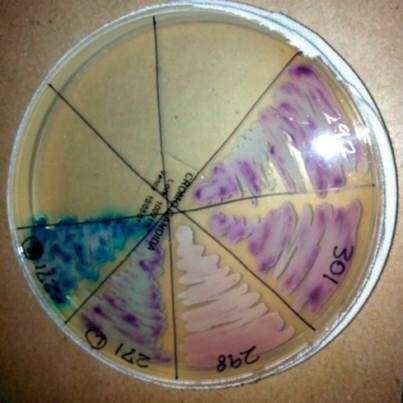

Resumen: El diagnóstico de las micosis constituye un problema clínico y terapéutico de interés actual debido al incremento y gravedad de las infecciones diseminadas. Por esta razón, en los últimos años se ha priorizado la búsqueda de nuevos métodos para el diagnóstico rápido y preciso. En la actualidad contamos con métodos tradicionales como KOH, cultivo, histopatología y serología, y, de forma más reciente, con métodos moleculares que permiten mayor rapidez y sensibilidad. En esta revisión se hace énfasis en la importancia de los métodos de diagnóstico micológico para la dermatología y la medicina general, ya que debido al desconocimiento en este campo, la preparación del paciente no es la adecuada y, por otro lado, la dificultad en la interpretación de los resultados lleva a confusión y tratamientos incorrectos.
Palabras claves: MicologíaMicología,DiagnósticoDiagnóstico,KOH, PCR, CultivosKOH, PCR, Cultivos,SerologíaSerología.
Abstract: Diagnosis of fungal infections is a clinical and therapeutic problem of current interest due to the increase and severity of disseminated infections. For this reason in recent years have been mainly seeking new methods for fast and accurate diagnosis. At present we have traditional methods like KOH, culture, histopathology and serology, and more recently molecular methods that allow greater speed and sensitivity in diagnosis. This review emphasizes the importance of mycological diagnosis methods for dermatology and general medicine, as due to ignorance in this field, patient preparation is not adequate and secondly the difficulty in interpreting results and treatment choice are misleading.
Keywords: Mycology, Diagnosis, KOH, PCR, Cultures, Serology.
Revisión de tema
Métodos de diagnóstico en micología
Diagnostic methods in mycology
Universidad CES
Recepción: 14 Mayo 2013
Recibido del documento revisado: 18 Octubre 2013
Aprobación: 23 Enero 2014
Las infecciones fúngicas pueden causar un gran número de manifestaciones clínicas que dependerán del lugar de la infección y de la respuesta inmunitaria del paciente. Su diagnóstico se establece sobre la base y sospecha clínica y los datos del laboratorio microbiológico. Sin duda, el diagnóstico microbiológico es esencial y cada vez se están desarrollando técnicas para un rápido diagnóstico 1,2.
El problema más frecuente es el elevado porcentaje de resultados negativos de las muestras, debido a factores tales como la inapropiada preparación del paciente, extracción inadecuada del material de las lesiones, fallas en su transporte y procesamiento, falta de experiencia del personal que realiza el examen micológico o la identificación e interpretación de los mismos.
De ahí la importancia de establecer protocolos institucionales para el correcto uso de los métodos diagnósticos en micología y capacitar al personal de salud en estos aspectos 3,4. A continuación se hará énfasis en los aspectos más relevantes para mejorar el diagnóstico microbiológico de las micosis y se expondrán los métodos más utilizados con sus características y avances actuales.
Entre las recomendaciones que debe darse al paciente están: suspender los medicamentos sistémicos o tópicos con acción antimicótica 15 días antes de la toma de la muestra y cinco días antes debe evitarse la aplicación de cremas o polvos sobre la piel a estudiar.
Preparación del paciente
Generalidades
Se ha observado que la preparación del paciente es una etapa muy importante previa a la toma de la muestra 5. Entre las recomendaciones que debe darse al paciente están: suspender los medicamentos sistémicos o tópicos con acción antimicótica 15 días antes de la toma de la muestra y cinco días antes debe evitarse la aplicación de cremas o polvos sobre la piel a estudiar. En el caso de tomar material de uñas se recomienda no cortarlas en la semana anterior a la obtención, ni usar esmalte y si la muestra que se va a tomar es de los pies se debe recomendar al paciente el uso de calzado cerrado 5.
Estas medidas aumentan el porcentaje de exámenes directos y cultivos positivos, reducen la contaminación y evitan partículas que impiden la visualización de las estructuras 5.
Toma de muestra
Para optimizar la toma de muestra es necesario seguir los siguientes pasos:
- Antes de realizar la recog.
- ida de la muestra deben limpiarse con etanol al 70 % la piel, pelos o uñas afectados para eliminar bacterias, exudación o residuos de tratamientos tópicos aplicados previamente, que dificultan el examen directo y el cultivo.
- Tomar la muestra utilizando contenedores estériles y enviarla antes de dos horas al laboratorio y proceder a estudiarlas rápidamente.
- Cuando se sospechan dermatofitos la muestra debe recogerse antes de iniciar el tratamiento y siempre de la parte activa de la lesión.
- Las muestras de lesiones abscedadas deben ser aspiradas con jeringa y colocadas en tubo estéril.
- La toma de muestra debe realizarse de acuerdo al sitio y tipo de lesión 6:
Si las lesiones son descamativas se debe raspar el borde activo con una hoja de bisturí, ya que dicho borde es el que probablemente contenga más elementos fúngicos viables. Si las lesiones son exudativas, el material se toma con un aplicador estéril. El material obtenido se recoge en un sobre o placa de Petri, con el fin de mantenerlo seco y libre de contaminación.
Hay una técnica alternativa para la toma de muestra de lesiones que presentan escasa descamación, llamada papel sello, y que consiste en la aplicación de la zona pegante de una cinta sobre la zona afectada, se presiona sobre la piel, se despega y se coloca sobre un portaobjetos. Este método es muy usado para el diagnóstico de la pitiriasis versicolor.
En el pelo depende del tipo de lesión observada: en la piedra blanca o negra las lesiones se localizan en la vaina del pelo, por lo que debe cortarse la porción supra folicular de los pelos afectados. En los casos de tiña de la barba o del cuero cabelludo los pelos deben ser arrancados con la raíz intacta, puesto que al cortarlos se elimina la visualización completa del pelo y su bulbo en donde se evidenciará el ataque ectorix o endotrix de la vaina del pelo. En la tiña favosa la muestra debe ser tomada con asa para las lesiones exudativas foliculares y con cucharilla para las escútulas 6,7.
En las onicomicosis depende del sitio en donde se encuentra la lesión: si es en el borde distal y lateral subungueal debe tomarse del material subungueal y de la zona más proximal de la lámina ungueal que, aunque es una zona de difícil obtención de la muestra, es la más fiable por la menor probabilidad de contaminación y además presenta elementos fúngicos viables (figura 1).

Figura 1.
Toma de muestra de onicomicosis distal
En caso de paroniquia crónica por posible candidiasis la muestra se toma del material más cercano a la cutícula, raspando con el bisturí en el surco periungueal y con un aplicador estéril se obtiene el material exudativo. Cuando hay compromiso proximal subungueal se debe tomar del material pigmentado de la zona más profunda de la lámina ungueal cercana a la cutícula 7,8. Para recoger la muestra en la onicomicosis superficial se raspa la superficie afectada con el escalpelo y para la distrófica total se debe raspar preferentemente el material subungueal 9,10. Luego de la toma de muestra adecuada se procede al examen microscópico directo.
Examen microscópico directo
Es el medio más rápido y sencillo de detectar una infección micótica. Cuando se encuentra un número suficiente de estructuras fúngicas se puede hacer un diagnóstico presuntivo y ocasionalmente definitivo como en el caso de la pitiriasis versicolor, lo que permite iniciar tempranamente el tratamiento 11,12.
El examen directo se realiza en fresco utilizando sustancias que ayudan a la digestión de las proteínas, aclaran pigmentos y despegan las células queratinizadas; además, estas sustancias facilitan la observación de las estructuras fúngicas por su alto índice de refracción 13,14.
El examen microscópico tiene limitaciones que están relacionadas con la experticia del personal que realiza la lectura del examen y la preparación del paciente para la toma de la muestra. El uso de antimicóticos tópicos, cremas, esmaltes de uñas, entre otros, afecta el resultado. Es por esta razón que los falsos positivos y la baja sensibilidad diagnóstica son factores que deben considerarse 15,16.
En la práctica, la solución más usada para el examen microscópico es el hidróxido de potasio (KOH), que disuelve la queratina y digiere parcialmente los componentes protéicos, pero no actúa sobre los polisacáridos de las paredes celulares de los hongos, facilitando así la visualización de los elementos fúngicos. Se usa a concentraciones de 20 % para uñas y 10 % para otras muestras. A esta solución se le pueden añadir otros compuestos como el glicerol para prevenir la degradación de los elementos fúngicos, formación de cristales y la deshidratación de la preparación.
También se le puede añadir dimetilsulfóxido que evita la necesidad del calentamiento y la formación de artefactos, además acelera la clarificación de la muestra. Aunque el método es barato y fácil de realizar, el problema es que requiere de una rápida visualización, puesto que puede producir artefactos visuales y generar confusión 16.
Para facilitar aún más el diagnóstico existen diferentes tinciones especiales, como el azul de metileno y la tinta Quink Parker®, que tiñen de azul intenso las estructuras fúngicas y ayudan a su reconocimiento, y la tinta china o nigrosina que permite observar levaduras capsuladas como en Cryptococcus spp. El azul de lactofenol es otra tinción especial que se realiza a partir de cultivos, en el cual el fenol destruye la flora acompañante, el ácido láctico conserva las estructuras fúngicas y el azul algodón tiñe la quitina de la pared del hongo para ayudar en su identificación 13,16.
Al igual que con el KOH debe tenerse precaución a la hora de la interpretación por la presencia de artefactos como burbujas de aire, hilo, algodón y agregados de lípidos (efecto mosaico) que pueden confundirse con estructuras micóticas y producir falsos positivos 15.
Por otro lado, el uso reciente de flurocromos como el rojo Congo, que se une a polisa-cáridos de la pared celular fúngica, facilita la detección de elementos fúngicos, pero este método está en desuso por el riesgo de carcinogénesis. El calcoflúor blanco se basa en la propiedad que tiene dicha sustancia de emitir fluorescencia al ser activada por radiación ultravioleta y por la afinidad que presenta por la celulosa y la quitina, presentes en la pared celular de los organismos fúngicos.
Este se ha considerado como un método rápido y fácil para la identificación de estructuras micóticas y requiere menor entrenamiento que el examen directo; sin embargo, tiene falsos positivos con fibras vegetales, colágeno o elastina, además requiere de microscopio de fluorescencia, el cual no está disponible en todos los laboratorios 17-19.
Cultivo
A pesar de la gran utilidad del examen directo, la prueba de oro para el diagnóstico definitivo, en la mayoría de los casos es el cultivo, pues permite establecer género y especie, lo cual tiene importancia tanto epidemiológica, como en la selección del tratamiento 13.
Las muestras deben ser procesadas rápidamente, empleando desde tubos hasta placas de Petri. Los medios más usados son el agar glucosado Sabouraud (figura 2) sin o con antimicrobianos como cloranfenicol y gentamicina para inhibir la contaminación bacteriana, un medio con cicloheximida para inhibir el crecimiento de hongos saprofíticos, excepto si se sospecha que el microrganismo sea Candida no albicans, Scopulariopsis spp, Acremonium spp, Aspergillus spp, Fusarium spp o Scytalidium spp, ya que estos son sensibles a dicho antifúngico. Para las micosis sistémicas el agar infusión cerebro - corazón es el medio indicado de siembra de la muestra 20.

Figura 2.
Medio de cultivo agar Sabouraud
Hay otro tipo de medios de cultivo diferenciales que se utiliza para ayudar a la identificación del hongo basado en la morfología y color de las colonias. Un ejemplo de este, es un medio cromogénico que permite visualizar de forma rápida las colonias pertenecientes a C. albicans y a otras especies de levaduras como C. tropicalis, C. lusitaniae y C. guilliermondii.
Este medio ha demostrado alta sensibilidad y especificidad, con muy pocos falsos positivos o negativos y ha venido remplazando las técnicas convencionales de identificación de C. albicans, como la producción de tubo germinal en suero o de cla-midosporas en agar harina de maíz o de arroz, que en ocasiones presentan falsos negativos 21,22.
También se han usado medios específicos para las especies de levaduras como el medio CHROMagar Candida que permite diferenciar C. albicans, C. tropicalis, C. krusei, y C. glabrata, en función de los colores que desarrollan en este medio (foto 3).

Figura 3.
Medio CHROMagarCandid
Usualmente, los cultivos se incuban a temperaturas entre los 25-30 °C, aunque especies como Trichophyton verrucosum requieren temperaturas más altas. La temperatura de 37 °C debe reservarse para hongos dimórficos como Histoplasma capsulatum, Blastomyces dermatitidis, entre otros. De la misma manera, los tiempos de incubación varían en función de la especie: por un lado, los dermatofitos crecen entre 7-28 días, mientras que otros hongos como Aspergillus spp, Scytalidium spp y las levaduras pueden ser identificados en pocas horas hasta una semana 4,23. En general, se considera que deben incubarse durante tres a cuatro semanas antes de ser desechados 24.
Luego del crecimiento de la colonia se hace un análisis macroscópico y microscópico. Algunas características como la coloración de las colonias y su textura pueden ayudar a identificar las diferentes especies, pero son los hallazgos microscópicos los que en última instancia determinan su identificación en la mayoría de los casos 25.
Histopatología
Es un método de gran utilidad no solo para confirmar sino también para realizar el diagnóstico en casos de difícil identificación o aislamiento del microrganismo con los métodos tradicionales, como sucede con las micosis profundas. Permite observar la causa de la lesión, los cambios histopatológicos que se generan, así como la respuesta inflamatoria que producen en los tejidos. Generalmente, el espécimen quirúrgico se recibe conservado en formol al 10 %, al que pueden realizársele técnicas de inmu-noflorescencia o conservar porciones en congelación para un posterior estudio.
Las tinciones de rutina para realizar la histopatología son la hematoxilina- eosina, junto con el PAS y el Grocott o plata metenamina, que constituyen las tinciones básicas para el estudio de las micosis. Hay también tinciones opcionales como la de Fontana-Masson para el estudio de pigmento melánico, importante en las feohifomicosis y las tinciones para mucipolisacáridos, como la de mucicarmin, básicas para el estudio de Cryptococcus spp y otros hongos que en su pared o cápsula contengan glucoproteínas (figura 4 y 5).

Figura 4..
Tincioncon hematoxilina-eosina en cromomicosis

Figura 5.
Tinción de metenamina en paracoccidioidomicosis
El patólogo, una vez procesada la muestra, puede observar bajo el microscopio las diferentes estructuras micóticas tales como hifas y esporas o conidias, pigmentadas o no. Conociendo los cambios tisulares que se producen en los tejidos y las diferentes morfologías puede llevar a clasificarlos y ofrecer un diagnóstico 25-27.
Serología
Se emplea generalmente en el diagnóstico de las micosis invasoras o sistémicas en las que por las condiciones del paciente y por la dificultad para la toma de muestras profundas se requiere de un método fácil, rápido y fiable para la identificación del agente causal. Aquí se encuentra la detección, tanto de antígenos fúngicos, como la respuesta de anticuerpos que se produce durante el desarrollo de la micosis y de componentes fúngicos no antigénicos 28,29.
Algunas de estas técnicas se han convertido en herramientas básicas en el laboratorio, como la detección del antígeno capsular de Cryptococcus neoformans por medio de aglutinación 30. También está la detección de galactomanano por la técnica de ELISA en pacientes con aspergilosis invasora y que ha demostrado ser más sensible que el látex y puede ser positiva desde antes de que aparezcan los síntomas clínicos 31,32.
Para las formas de candidiasis invasora la detección de manano parece ser más sensible. El gran problema es que la antigenemia en estos pacientes es transitoria, por lo que es posible que se necesite la combinación de técnicas que detecten diferentes antígenos o epítopes para aumentar la sensibilidad diagnóstica 33.
En relación a los métodos basados en medición de anticuerpos, esta respuesta puede estar retrasada, reducida o no existir en pacientes inmuno-comprometidos; sin embargo, estos problemas podrían resolverse eligiendo los antígenos apropiados y utilizando técnicas sensibles para detectar títulos bajos de anticuerpos. Las pruebas deben utilizarse para estudiar muestras seriadas del paciente, lo que permite analizar la evolución de los títulos de anticuerpos y su correlación con los datos clínicos y microbiológicos 12,34.
La detección de componentes no antigénicos liberados por los hongos durante la infección es otra posibilidad en el diagnóstico de las micosis. Uno es el D-arabinitol, un metabolito producido en candidiasis invasora y el H-D-glucano producido por Candida spp, Aspergillus spp y Pneumocystis spp 33-35,36.
Debido a las dificultades con los métodos diagnósticos tradicionales, entre los cuales se encuentra la falta de especificidad y sensibilidad, la difícil interpretación si se realiza por personal sin experiencia y el tiempo requerido para obtener los resultados y poder iniciar un tratamiento adecuado, se plantea la necesidad de buscar nuevos métodos que permitan realizar un diagnóstico oportuno y preciso. Por estas razones se implementaron las técnicas moleculares 37,38.
Métodos de diagnóstico molecular
Existen múltiples métodos para el diagnóstico por medio de la biología molecular, entre los que se encuentran métodos de amplificación de señal -que utilizan técnicas de hibridación de ácidos nucleicos- y técnicas de reacción en cadena de la polimerasa (PCR) -usada para el diagnóstico de aspergilosis y dermatofitos- 39-43.
Existen otras técnicas moleculares, como la amplificación de genes específicos por reacción en cadena de polimerasa, la amplificación de secuencias aleatorias, la amplificación de genes housekeeping y la amplificación de secuencias repetidas de ADN; sin embargo, son muy costosos y por esto actualmente solo se usan para investigación y ocasionalmente como método diagnóstico en casos difíciles 44-46.
Para la identificación de los géneros Aspergillus spp y Candida spp se ha logrado el diagnóstico rápido de las 12 especies patógenas más comunes, utilizando sondas de captura diseñadas a partir de secuencias específicas de ADN y de genes que codifican para el ARN ribosómico 47,48. Este método denominado microarreglos (microarrays, en inglés) se basa en el principio de hibridación específica entre ácidos nucléicos, en este caso, un RNA mensajero y la molécula de DNA de la cual deriva por transcripción 49.
Se han desarrollado tecnologías basadas en la proteómica que consiste en analizar los patrones globales de expresión de proteínas en un organismo, las cuales usan técnicas tales como la electroforesis y otros como los microarreglos de proteínas que tienen gran utilidad, no solo en los estudios de investigación, sino también en el diagnóstico y en la búsqueda de nuevos tratamientos en micología 50-53.
Aunque los métodos convencionales siguen siendo la herramienta fundamental para el diagnóstico en micología dado su facilidad y accesibilidad, requieren de ciertos parámetros como la adecuada obtención y procesamiento de la muestra y un análisis meticuloso por personal entrenado para obtener resultados confiables. Con la aplicación de la biología molecular y los avances en la genómica se ha logrado aumentar la sensibilidad y rapidez del diagnóstico de una gran variedad de micosis, facilitando así el inicio oportuno de un tratamiento.

Figura 1.
Toma de muestra de onicomicosis distal
Figura 2.
Medio de cultivo agar Sabouraud
Figura 3.
Medio CHROMagarCandid

Figura 4..
Tincioncon hematoxilina-eosina en cromomicosis

Figura 5.
Tinción de metenamina en paracoccidioidomicosis
